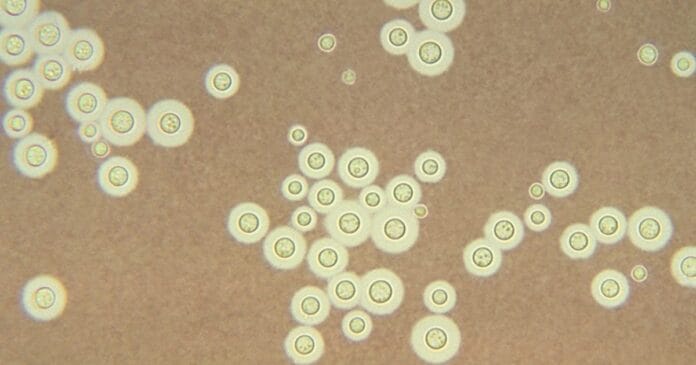
Cryptococcus neoformans

A report on what’s claimed to be the first study to definitively link an infection in a patient to a pathogen in medical cannabis has been published.
Many patients with various conditions are using medical cannabis to address symptoms of their disease and mitigate side effects of other treatments. But it’s often been warned that contaminants in cannabis such as fungus can present a risk to patients; particularly those with compromised immune systems — although there’s been little proof of this actually happening.
Researchers from the University of Pittsburgh may have been the first to demonstrate such an infection.
The researchers recorded the details of a case of a 46-year-old Pennsylvania woman with relapsing multiple myeloma following a stem cell transplant, who was treated with daratumumab (immunotherapy), pomalidomide (chemotherapy) and dexamethasone (steroid).
When presenting after several months of dysphonia (voice hoarseness), worsening sore throat and new-onset headache, she was diagnosed with Cryptococcus neoformans epiglottitis/laryngitis and meningitis. Cryptococcus is an invasive fungus that is transmitted through the inhalation of spores.
After various treatments she presented with septic shock from bacterial urosepsis and then hospital-acquired pneumonia. She subsequently developed arrhythmia and died from cardiac arrest. An autopsy indicated persistent cryptococcosis involving the epiglottis, lungs and visceral pleura, and superimposed bronchopneumonia.
While cryptococcal laryngitis is uncommon and inhaled corticosteroid is a common risk factor, the patient denied inhaled or nebulized steroid use (dexmethasone is usually a tablet). However, the patient acknowledged using medical cannabis, including loose dried marijuana flower, vape cartridges (distillate) and wax purchased legally in the state from authorised dispensaries.
Initially, moulds including Aspergillus fumigatus, A. flavus, A. niger, Fusarium and Penicillium species were cultured from all flowers, distillate and wax samples; but not C. neoformans. After modifying culturing methods, Cryptopcoccus neoformans was detected, originating from one of the flower products. The researchers were able to match the fungal strain from the patient’s cannabis product, verifying cannabis flower as the source of the infection.
The researchers concluded:
“With growing demand for nonopioid analgesics and increased medical cannabis usage, there is clear need for rigorous clinical studies and greater regulation of cannabis products.”
The report has been published in the journal Clinical Infectious Diseases.
On a related note, a recent survey found most cannabis consumers in the USA want their cannabis decontaminated.